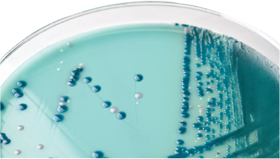

Novice
NEW OXOID READY PLATES
SAVES TIME
• Results in just 18 hours, helping minimize the opportunity for transmission
REDUCES COSTS
• Identify CRE colonized patients earlier, for more targeted treatment and
better patient outcomes
EASY TO READ
• Clearly differentiated CRE colonies
• The novel pigmented background makes it easy to spot other (non-
CRE) resistant organisms, like Acinetobacter
CONVENIENT AND EASY TO USE
• Direct inoculation from patient sample; swab, stool or urine
• Much simpler to perform and interpret than Modifi ed Hodge Test
Oxoid Brilliance CRE Agar
Brilliance CRE Agar makes detecting patients colonized with carbapenem-resistant Enterobacteriaceae (CRE) easy, reducing the need to perform complex confi rmational methods, such as Modifi ed Hodge Test.The formulation contains a modifi ed carbapenemat a level recommended by both EUCAST and CLSI,ensuring reliable results with a wide variety ofCRE, including those with the New Delhi Metalloß-lactamase 1 (NDM-1) mechanism.The two-chromogen system differentiates E. coli
(pink) from the Klebsiella, Enterobacter, Serratia and Citrobacter (KESC) group, which grow blue.The novel background makes the white or naturally pigmented colonies of non-CRE organisms, such as Acinetobacter, easy to spot, and results are available in just 18 hours.
Performance
Carbapenems (imipenem, meropenem, ertapenem and doripenem) are invaluable for the treatment of infections due to multiresistant, Gram-negative bacteria, including producers of
extended-spectrum ß-lactamases (ESBL)1. However, the rapid emergence and dissemination of Enterobacteriaceae that are resistant to carbapenems poses a considerable threat to clinical patient care and public health2. Early detection of carbapenem-resistant Enterobacteriaceae (CRE) will allow faster implementation of appropriate strategies to limit the spread of these pathogens.
Brilliance CRE Agar was evaluated, alongside MacConkey Agar with 1μg/mL imipenem3 and a competitor agar “K”, for the detection of CRE (according to European Committee on
Antimicrobial Susceptibility Testing (EUCAST) guidelines4) , using a panel of geographically diverse isolates. The panel comprised 43 CRE, seven other carbapenem-resistant organisms, including Acinetobacter spp. and Pseudomonas spp., and 99 carbapenem-sensitive organisms.
Brilliance CRE MacConkey Agar Competitor “K”
Agar + 1μg/mL imipenem Agar
Inclusivity at 16–18 hours 97.7% 74.4% 88.4%
Brilliance CRE Agar detected more CRE than the competitor Agar or MacConkey Agar with
1μg/mL imipenem, making it an effective tool for detecting CRE and other carbapenemresistant
organisms in just 18 hours. Faster results enable prompt initiation of appropriate
infection control measures to help minimize opportunities for further transmission of CRE.
Identifi cations are presumptive and should be confi rmed.
M.I.C.EvaluatorsTM
For the accurate determination of the minimum inhibitory concentration (MIC) of a test
organism to an antimicrobial
Imipenem (IPM) 32–0.002μg/mL 10 test strips MA0115D
Imipenem (IPM) 32–0.002μg/mL 50 test strips MA0115F
Meropenem (MEM) 32–0.002μg/mL 10 test strips MA0121D
Meropenem (MEM) 32–0.002μg/mL 50 test strips MA0121F
Tigecycline (TGC) 256–0.015μg/mL 10 test strips MA0124D
Tigecycline (TGC) 256–0.015μg/mL 50 test strips MA0124F
Antimicrobial Susceptibility Testing Discs
Colistin (CT) 10μg 5x50 discs CT0017B
Colistin (CT) 25μg 5x50 discs CT0065B
Doripenem (DOR) 10μg 5x50 discs CT1880B
Ertapenem (ETP) 10μg 5x50 discs CT1761B
Fosfomycin (FOS) 50μg 5x50 discs CT0183B
Imipenem (IMP) 10μg 5x50 discs CT0455B
Meropenem (MEM) 10μg 5x50 discs CT0774B
Tigecycline (TGC) 15μg 5x50 discs CT1841B
Kontaktni podatki
ReMaS d.o.o.
Koseška cesta 8
1000 Ljubljana
Davčna številka: SI37978870
Matična številka: 5748704
Tekoči računi podjetja:
NLB: 02010-0014150326
SKB: 03170-1000444776
E: remas@siol.net
WWW: www.remas.si
T: 01 5819205 in 01 5819204
F: 01 5819232
M: 040 633820 in 040427082
Novice
- Papua 2017 - medicinska odprava na Papuo Novo Gvinejo
- Illumigene® Mycoplasma (REF. 280550)
- Novi Merdian-ov test za klamidijo in gonorejo
- Ocena dobaviteljev ZZV Maribor
- Novo zastopstvo v podjetju ReMas
- EUROIMMUN AG gains 5th place in the “TOP 100 Small and Medium-Sized Enterprises”
- ILLUMIGENE STREP A
- ILLUMIGENE GBS
- NEW OXOID
READY PLATES
Računovodski servis
TRAKO d.o.o.
Lučka Gabrijelčič
T: 01 430 44 31
F: 01 430 44 33
